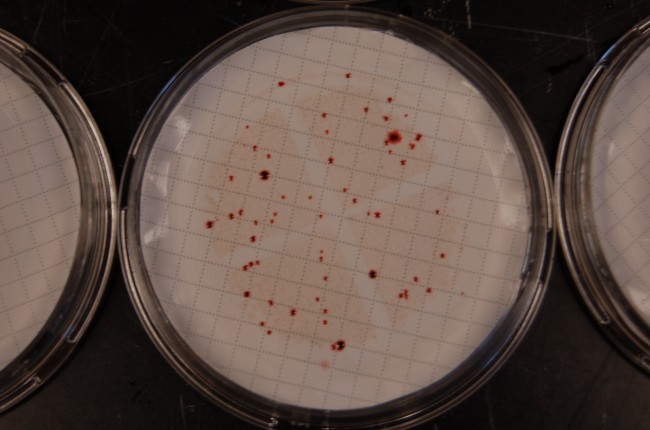
Portland

The Oregon Department of Transportation (ODOT) has closed I-84 between The Dalles and Cascade Locks as a result of an

The National Weather Service (NWS) issued several wind advisories for the states of Oregon, Washington, and Northern California on March 9,

A 22-year-old suspect was arrested early Saturday morning in connection with a shooting at a Portland, Oregon school. The incident

Oregon is becoming a battleground of opposition as Christian evangelical group Child Evangelism Fellowship (CEF) and citizen group Protect Portland

A shooting near Portland OR, with one student death and injuries suffered by both students and teachers, challenges the stereotype
Memorial Day weekend is starting off on a bad note for residents of Portland, Oregon, after the Water Bureau issued

Today, in his first formal press conference, Portland resident Jessie Sponberg announced a last-minute write-in campaign to be the next

The Multnomah County, Oregon Sheriff Dan Staton, was running uncontested. He had it in the bag, a slam-dunk cakewalk to